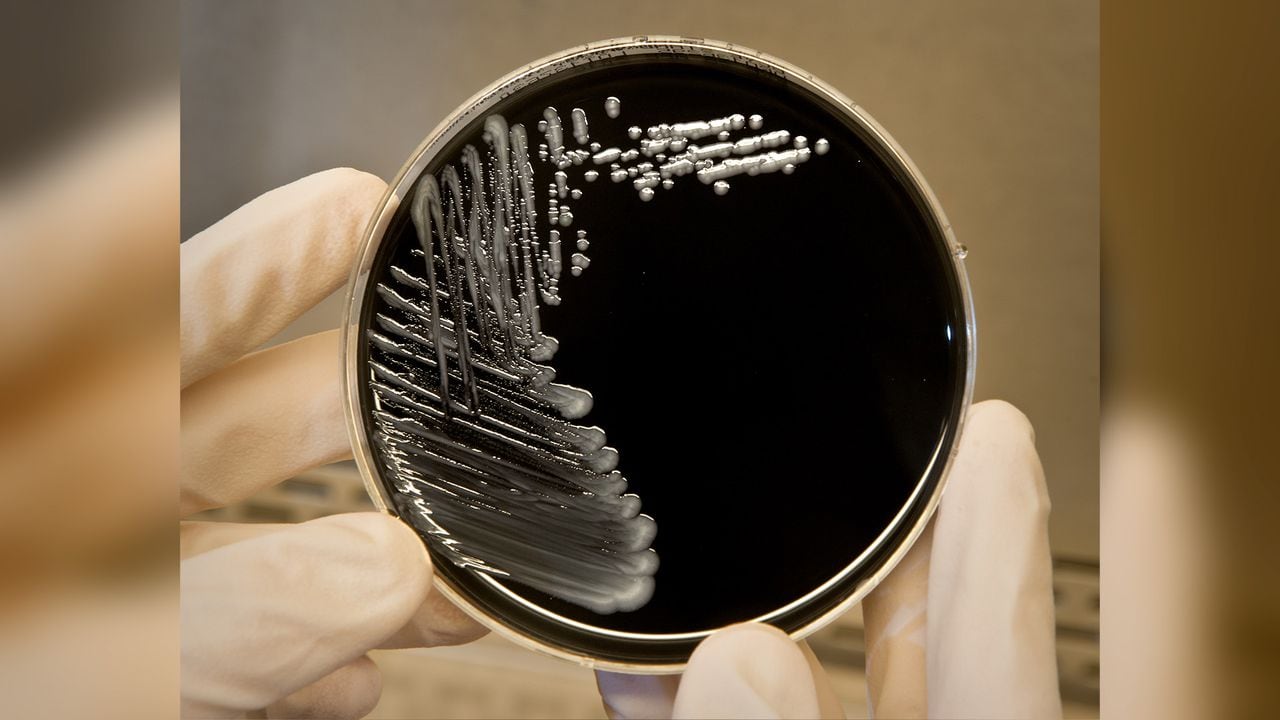
"Legionnaires' Outbreak at NH Resort: Symptoms and Concerns After Mass. Resident's Death"

"Legionnaires' Outbreak at NH Luxury Resort Claims Lives, Sparks Health Probe"
A 71-year-old woman, Barbara Kruschwitz, died from Legionnaires' disease after staying at the Mountain View Grand Resort & Spa in New Hampshire. Her husband suspects the hotel's water system, including the pool and hot tub, as the source. A second guest from Rhode Island was also hospitalized with the disease. New Hampshire health officials are investigating both cases, with no definitive link to the hotel's water system established yet. The hotel has closed the hot tub and is working with health authorities while maintaining strict safety protocols. Symptoms of Legionnaires' disease appear 2-14 days after exposure, and anyone with symptoms after staying at the resort is advised to get tested.